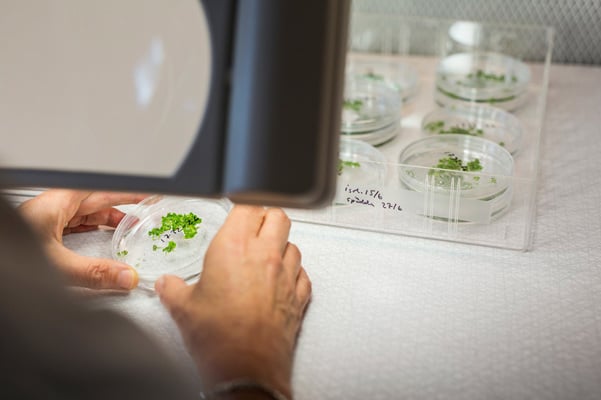

Lantmännen is an agricultural cooperative and Northern Europe’s leader in agriculture, machinery, bioenergy and food products.
Lantmännen’s knowledge and operations in every stage represent an opportunity to drive and contribute to development in the value chain of grains. We focus on research that can develop and move the entire grain sector forward.
Lantmännen operates in a common structure for research and development. Each business area respectively drives the development that lies closest to its business. Strategic, long term research projects are coordinated at a central level by the Lantmännen R&D department, who also run the Lantmännen Research Foundation as well as the group’s overall innovation process.
Lantmännen R&D brings together the Lantmännen group’s experts within research, innovation and scientific issues from field to fork. We work with a strategic project portfolio in close cooperation with Lantmännen’s different business areas. Lantmännen R&D is also responsible for the overall innovation process which means the identification, business development and implementation of ideas and research results for Lantmännen’s business.
The portfolio includes EU projects, projects partly financed by national research investments in the Nordic region as well as projects financed by the Lantmännen Research Foundation. Collaboration with institutes, suppliers and universities is an important part of these projects

Lantmännen has a long history of successful research projects that have resulted in product innovation, process improvements and a more efficient agriculture. At the moment, we are participating in approximately 40 research projects – within food, agriculture and energy – together with universities, institutes and suppliers. Over the years, we have participated in over 500 research projects and studies.
Innovation to Lantmännen can be easily expressed as creating something brand new that increases company profits. In order to do that, we need to match needs with possibilities – something that is best achieved through cooperation.
Cooperation is the key to some of our best innovations, for example products with documented low glycemic index, fiber products with specific medical benefits, bread that stays fresh longer in the consumer’s home, new tasty whole grain products like whole grain pasta, and functional food based on AS-factor and the Nordic diet.
Through many years of research collaborations we have also developed Cedemon and Cerall, biologically treated seeds certified for use in organic farming by the EU and KRAV. Our research has also covered precision farming with the aim of reducing energy consumption, plant nutrients and pesticides while simultaneously improving the quality of the crops.
With help from our research foundation, Lantmännen invests in external research at universities and colleges. We are interested in cooperating within several different fields, with both academia, government agencies and suppliers.
Please contact one of Lantmännen R&D’s research coordinators regarding future research projects.
Research Manager
Agriculture & Machinery

Food and health